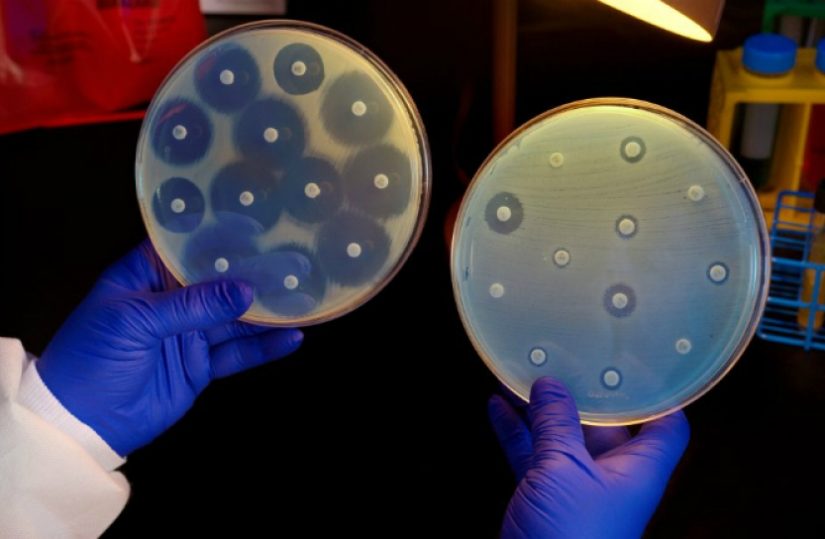

Foco
08 Nov 2018
OM alerta Governo para sucessivas falhas nos sistemas informáticos
“Não só são exigidos aos médicos cada vez mais procedimentos informáticos supérfluos, que só penalizam o tempo destinado a observar...08 Nov 2018
Pneumonia: MOVA promove rastreios e alerta para prevenção
Esta campanha pretende sensibilizar a população para a importância de prevenir a pneumonia, bem como dos respetivos problemas que estão...08 Nov 2018
Carlos Aguiar: “As doenças cardiovasculares são a principal causa de morte entre os diabéticos”
Para o médico, “a relação entre doenças cardiovasculares e diabetes é, do ponto de vista da saúde pública, preocupante e...08 Nov 2018
Maria de Belém: É natural que o Governo queira aperfeiçoar a Lei de Bases da Saúde
De acordo com a jurista, é “normal” que o projeto de proposta de lei seja analisado no âmbito do Governo,...08 Nov 2018
Governo dos Açores investe na acessibilidade à Saúde
“O reforço das verbas também está relacionado com a aposta na acessibilidade dos açorianos ao Serviço Regional de Saúde, com...08 Nov 2018
OMD defende criação de carreira para dentistas no SNS
Em declarações à agência Lusa, o bastonário da OMD, Orlando Monteiro da Silva, explicou que estes dois temas terão “lugar...07 Nov 2018
OCDE: Superbactérias podem causar mais de 40 mil mortes até 2050
De acordo com a Organização para a Cooperação e Desenvolvimento Económico (OCDE), Portugal exibe um dos mais altos resultados de...07 Nov 2018
Fórum Cuid’ART 2018 debate panorama da radioterapia em Portugal
O panorama da radioterapia em Portugal será um dos principais temas em destaque neste evento nacional, dirigido ao cuidado do...07 Nov 2018
CHULC recebe conferência sobre consentimento informado e esclarecido
Trata-se da 9.ª conferência, integrada no ciclo de conferências da campanha "Envolvimento do Doente na sua Segurança" que resulta da...07 Nov 2018
Congresso da OMD reúne mais de seis mil participantes na Exponor
Até agora, o evento soma já mais de seis mil inscrições (6.400), tornando-se, assim, no maior congresso da OMD de...07 Nov 2018
OE 2019: Ministra garante abertura de 40 USF até ao final da legislatura
“O que procuramos é que o nosso sistema esteja cada vez mais estruturado em torno dos cuidados de saúde primários,...07 Nov 2018
CHBM reforça recursos humanos com contratação de dez médicos
“Centrado na sua missão principal, a prestação de cuidados de saúde aos utentes da nossa área de influência, o CHBM...07 Nov 2018
Ministra: Lei de Bases da Saúde ainda pode ser aperfeiçoada
“Recebemos e analisámos com todo o cuidado os trabalhos da comissão que foi nomeada para proceder à revisão da Lei...07 Nov 2018
IPO Porto debate inovação digital no tratamento de doentes
O Meeting’18 irá abordar os desafios para a melhoria da qualidade da informação na prestação e gestão dos cuidados de...07 Nov 2018
Web Summit: Healthcare City procura novos projetos na área da Saúde
Os empreendedores têm 90 segundos para apresentar a ideia e tentar cativar o interesse da Healthcare City. No final da...06 Nov 2018